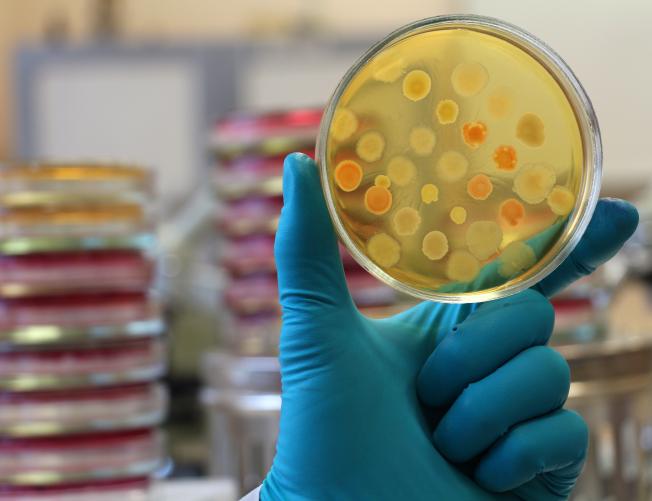
Gloved hand of laboratory technician holding a petri dish. Blurred petri plates stacks forms lab background.

Explore advanced topics with UC instructors and researchers
University of California, Santa Cruz invites motivated high school students to join a transformative academic journey through the Pre-College Summer Enrichment Program.
Each session provides an immersive introduction to a specialized area of study, combining college-level instruction, hands-on projects, and guest lectures from leaders in academia and industry.
Students collaborate in small teams, guided by UC student mentors, as they build essential skills in research, communication, and critical thinking. Each session concludes with a final project presentation to peers, instructors, and advisors—preparing students for the academic rigor of college and the demands of future careers.